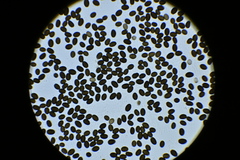

Coprinellus sclerocystidiosus: taxon details and analytics
- Domain
- Kingdom
- Fungi
- Phylum
- Basidiomycota
- Class
- Agaricomycetes
- Order
- Agaricales
- Family
- Psathyrellaceae
- Genus
- Coprinellus
- Species
- Coprinellus sclerocystidiosus
- Scientific Name
- Coprinellus sclerocystidiosus
Coprinellus sclerocystidiosus in languages:
- Dutch
- Bruindonzige inktzwam
- Finnish
- kystimustesieni
Images from inaturalist.org observations:
We recommend you sign up for this excellent, free service.
Parent Taxon
Sibling Taxa
- Coprinellus amphithallus
- Coprinellus angulatus
- Coprinellus aokii
- Coprinellus bisporiger
- Coprinellus bisporus
- Coprinellus brevisetulosus
- Coprinellus callinus
- Coprinellus canistri
- Coprinellus cinereopallidus
- Coprinellus congregatus
- Coprinellus doverii
- Coprinellus ephemerus
- Coprinellus eurysporus
- Coprinellus fuscocystidiatus
- Coprinellus heterosetulosus
- Coprinellus heterothrix
- Coprinellus hiascens
- Coprinellus impatiens
- Coprinellus limicola
- Coprinellus marculentus
- Coprinellus mitrinodulisporus
- Coprinellus pallidus
- Coprinellus pellucidus
- Coprinellus plagioporus
- Coprinellus pseudoamphithallus
- Coprinellus radicellus
- Coprinellus sabulicola
- Coprinellus sassii
- Coprinellus sclerocystidiosus
- Coprinellus subdisseminatus
- Coprinellus subimpatiens
- Coprinellus subpurpureus
- Coprinellus uljei
- Coprinellus velatopruinatus